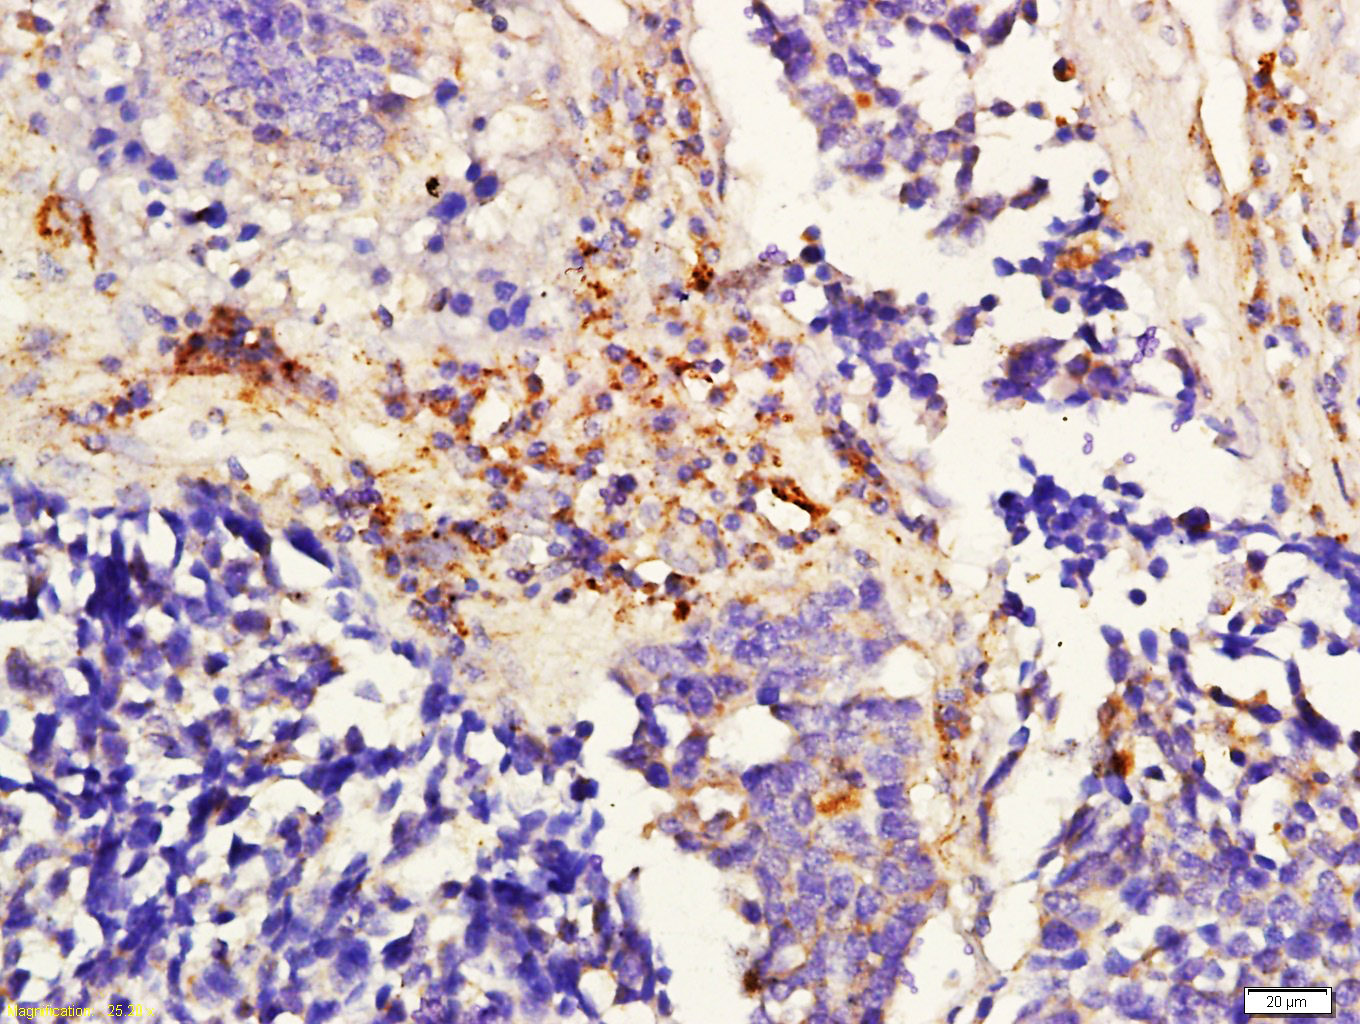

worldwide@absin.cn
- Cart 0
- English
Rabbit anti-ADORA2B Polyclonal Antibody
Adenosine A2b Receptor; adora 2; adora 2b; ADORA2; ADORA2B; HGNC:264; Netrin 1 receptor; AA2BR_HUMAN,ADORA2B

Reactivity:
Human, Rat
Application:
WB, IHC-F, IHC-P, IF
Host:
Rabbit
Clonality:
Polyclonal Antibody
 Request bulk quotation
Request bulk quotation- Product Details
- FAQ
- Pictures
- Documents
Tips : This product is for research use only. Not for use in diagnostic prodcedures.
